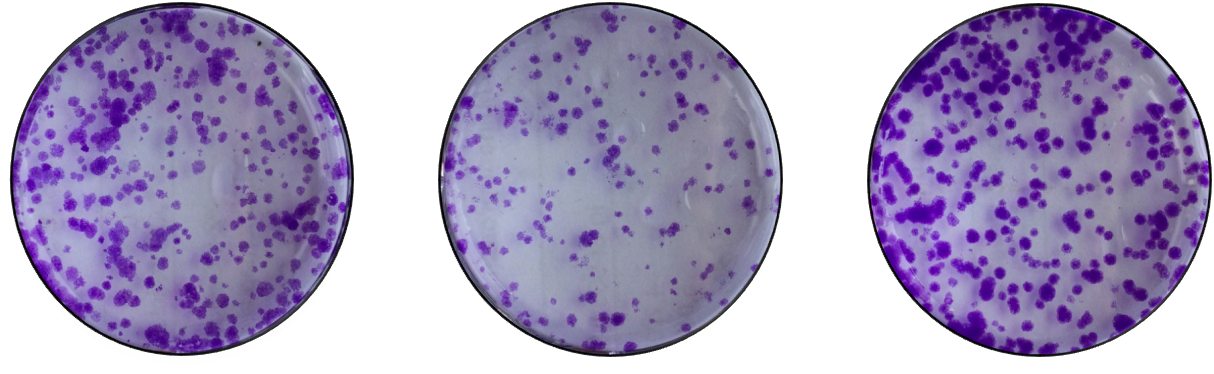

参考文献
Joung J, Konermann S, Gootenberg JS, Abudayyeh OO, Platt RJ, Brigham MD, Sanjana NE, Zhang F. Author Correction: Genome-scale CRISPR-Cas9 knockout and transcriptional activation screening. Nat Protoc. 2019 Jul;14(7):2259. doi: 10.1038/s41596-018-0063-0. Erratum for: Nat Protoc. 2017 Apr;12(4):828-863. PMID: 30349047.
在电子耦合试剂存在的情况下,WST-8(化学名:2-(2-甲氧基-4-硝苯基)-3-(4-硝苯基)-5-(2,4-二磺基苯)-2H-四唑单钠盐),可以被线粒体内的脱氢酶还原生成高度水溶性的橙黄色的甲臜产物(formazan),其颜色的深浅与细胞增殖成正比,与细胞毒性成反比,对于同样的细胞,颜色的深浅和细胞数目呈线性关系。使用酶标仪在450nm波长处测定OD值,可以间接反映活细胞的数量。

Figure 1(引用自文献1)
· 细胞培养,离心去上清,重悬后,细胞计数。
· 细胞于96孔板中铺板,100uL/孔。
· 培养24小时后,根据实验条件处理细胞。
· 继续培养细胞24H,48H,72H,加入CCK8试剂检测OD值。

细胞周期(cell cycle )指从一次细胞分裂形成子细胞开始到下一次细胞分裂形成子细胞为止所经历的过程,它反映了细胞增殖的速度。通常由G0/G1期、S期、G2期和M期组成。

Figure 2(引用自文献2)
PI法是经典的周期检测方法。PI为插入性核酸荧光染料,能选择性的嵌入核酸DNA和RNA双链螺旋的碱基之间与其结合,其结合的量与DNA的含量成正比例关系,用流式细胞仪进行分析,就可以得到细胞周期各个阶段的DNA分布状态,从而计算出各个期的百分含量。
· 细胞按照一定实验条件处理后,离心收集。
· PBS清洗细胞,离心,弃去上清。
· 加入PI染液,孵育。
· 流式检测,数据处理。

细胞克隆形成实验是用来检测细胞增殖能力的重要技术方法。
当单个细胞在体外增殖6代以上,其后代所组成的细胞群体,形成集落或克隆。每个克隆大概含有50个细胞以上。细胞克隆形成率即细胞接种存活率,表示接种细胞后贴壁的细胞成活并形成克隆的数量。克隆形成率反映了细胞群体依赖性和细胞增殖能力两个重要性状。
贴壁后的细胞不一定每个都能增殖和形成克隆,而形成克隆的细胞必为贴壁和有增殖活力的细胞。
· 制备细胞悬液:取对数生长期细胞,常规消化。
· 每组样品按500个细胞/6孔进行铺板,每组重复3个复孔,补10%FBS的培养基至3ml,吹打成单细胞悬液,置于培养基培养。
· 当细胞形成细胞团时(一个细胞团50个细胞左右),弃去培养基,PBS清洗2遍,加入1ml 4%多聚甲醛或甲醇固定液固定10min。
· 弃去固定液,PBS清洗2遍,加入1ml结晶紫染液染色20min。
· 弃去染色液,PBS清洗3遍洗掉底部的染色,并进行拍照。
· 数据处理。
细胞生长曲线是测定细胞活力的重要指标之一,是培养细胞生物学特性的基本参数,生长曲线也可以测定外在条件(药物等)对其细胞活力的影响。
细胞消化后接种到培养皿中贴壁,一般随后会经过延滞期,对数期,平台期。而在细胞处于对数生长期达到汇合之前就需要进行传代。

· 细胞消化,培养基制备成单细胞悬液,计数,按照细胞类型将一定数量的细胞接种至培养板,加入培养基。
· 每天取3孔细胞消化,计数,计算平均值。一般需连续计数10天左右。
· 以培养时间为横轴,细胞浓度为纵轴,绘制生长曲线。

1、实验原理
(1)基于凋亡的早期细胞膜上的磷脂酰丝氨酸(phosphotidylserine, PS)从细胞膜的内侧翻转到细胞膜的表面这一原理来实现的。
(2)Annexin Ⅴ(膜联蛋白 V)是一种分子量为35-36 kDa的Ca2+依赖性磷脂结合蛋白,能与PS高亲和力结合,将Annexin V 进行荧光素FITC标记,利用流式细胞仪或荧光显微镜可检测细胞凋亡的发生。
(3)碘化丙啶(Propidium, PI)是一种可与DNA结合的染料,它不能透过正常细胞或早期凋亡细胞的完整的细胞膜,但在凋亡中晚期的细胞和死细胞,PI 能够透过细胞膜而使细胞核红染。
(4)Annexin V与PI联合使用时,便可用来鉴别活细胞,凋亡细胞及死亡细胞。
2、实验流程
· 细胞消化(使用不含EDTA的胰酶),培养基制备成单细胞悬液,计数,按照试剂盒中需求的细胞数量收集细胞。
· 细胞用PBS清洗两遍,弃上清,加入染料,孵育。
· 流式检测。
3、实验案例

当细胞长到融合成单层状态时,在融合的单层细胞上用塑料枪头人为制造一个空白区域,称为“划痕”,划痕边缘的细胞会逐渐进入空白区域使“划痕”愈合,在一定程度上模拟了体内细胞迁移过程。
· 制备细胞悬液:取对数生长期细胞,常规消化。
· 用含10%FBS的培养基重悬细胞,血球计数板进行计数,按1×106个/ml(可根据细胞生长速度调整)进行铺板。
· 第二天显微镜下观察细胞,细胞汇合度达到70%-80%进行处理。(可以是转染或者加药等)。
· 处理一定时间后观察细胞,汇合度基本要达到100%,吸去上清培养基,无菌PBS清洗2遍,加入1 ml 含1%FBS的培养基。
· 将6孔板盖用酒精棉球轻轻擦拭干净,放在需要划线的上方,用200ul的枪头沿6孔板盖边沿用力均匀进行“井”字划线(选取的100ul的枪头边缘要平整)。
· 划痕结束后吸去培养基,无菌PBS清洗2遍,将划掉的细胞清洗掉,加入2ml含1%FBS的培养基,在显微镜下选取视野进行0h拍照(拍3-5张,尽可能标记位置)。
· 分别培养24h、48h后在显微镜下的标记位置处再次进行拍照。
· 数据处理,计算迁移率。

· 将Transwell小室放入培养板中,小室内称上室,培养板内称下室,上室内盛装上层培养液,下室内盛装下层培养液,上下层培养液以聚碳酸酯膜相隔。我们将细胞种在上室内,由于聚碳酸酯膜有通透性,下层培养液中的成分可以影响到上室内的细胞,从而可以研究下层培养液中的成分对细胞生长、运动等的影响。
· 应用不同孔径和经过不同处理的聚碳酸酯膜,就可以进行共培养、细胞趋化、细胞迁移、细胞侵袭等多种方面的研究。侵袭实验中使用到的Matrigel 是从小鼠EHS肉瘤中提取的基质成分,含有LN、IV型胶原、接触蛋白和肝素硫酸多糖,铺在无聚乙烯吡硌烷酮的聚碳酸酯滤膜上,能在DMEM培养基中重建形成膜结构,这种膜结构与天然基质膜结构极为相似。
· Transwell小室的滤膜孔径一般为8μm,在侵袭实验中,膜孔都被Matrigel覆盖,细胞不能自由穿过,必须分泌水解酶,并通过变形运动才能穿过这种铺有Martrigel 的滤膜,这与体内情况较为相似。细胞欲进入下室,先要分泌基质金属蛋白酶(MMPs)将基质胶降解,方可通过聚碳酸酯膜。计数进入下室的细胞量可反映肿瘤细胞的侵袭能力。

Figure 3(引用自百奥普生物)
· 制备细胞悬液:取对数生长期细胞,常规消化(消化前可以无血清饥饿12-24h,去除血清对细胞侵袭能力的影响)。
· 用含1%FBS的培养基重悬细胞,血球计数板进行计数,调整细胞密度为5×105/ml。
· 取100ul细胞悬液接种于transwell小室的上室(侵袭实验需要在上室提前铺上Martrigel基质胶),下室加入600ul含10%FBS的完全培养基(缓慢加入,避免产生气泡)。
· 培养细胞48h后,吸干上室液体,PBS清洗2遍后,放置于含800ul 4%多聚甲醛固定液或甲醇的24孔板内,室温固定30min。
· 将其在含PBS的24孔板内轻轻涮洗,吸干上室液体,将其转移至含800ul结晶紫染液(0.1%)中,室温染色20min。
· 将小室在含PBS的24孔板内轻轻涮洗3次进行脱色(也可用流动水轻轻冲洗浸泡)。
· 吸干上室液体,用棉签(棉花旋转扯松一点)轻轻旋转擦掉上室底膜表面未迁移的细胞。
· 显微镜下随机观察5个视野并进行拍照。
· 数据处理。

参考文献
[1]Chamchoy K, Pakotiprapha D, Pumirat P, Leartsakulpanich U, Boonyuen U. Application of WST-8 based colorimetric NAD(P)H detection for quantitative dehydrogenase assays. BMC Biochem. 2019 Apr 8;20(1):4. doi: 10.1186/s12858-019-0108-1. PMID: 30961528; PMCID: PMC6454709.
[2]Bernander R. The cell cycle of Sulfolobus. Mol Microbiol. 2007 Nov;66(3):557-62. doi: 10.1111/j.1365-2958.2007.05917.x. Epub 2007 Sep 17. PMID: 17877709.